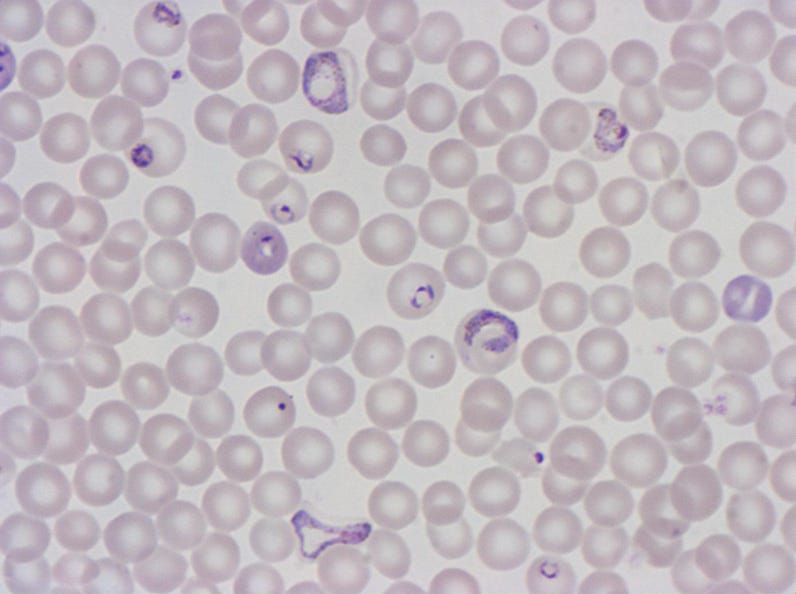

筏井 宏実
https://www.kitasato-u.ac.jp/vmas/lab/veterinary-parasitology-laboratory
寄生虫学者。
北里大学獣医学部准教授。
岐阜大学大学院連合獣医学研究科修了、博士(獣医学)。
専門は、主に寄生性原虫と媒介生物の相互関係。
これまでにマラリア・バベシア症に関する研究を中心に行う。国内外の寄生虫学系・獣医学系ジャーナルでの論文発表、学会での口頭発表など多数。最近の記事執筆に「One Healthの概念と人獣共通感染症:感染症と付き合うために理解しておくこと」(『ICNR』、2020年)などがある。

左の写真:遺伝子組換えした光るマラリア原虫を吸ったハマダラ蚊の像。蚊の腸の中と唾液腺の中でマラリア原虫が緑色に光っています。
マラリア原虫とは:ハマダラ蚊の唾液を介して動物に寄生するユニークな感染様式を持っています。動物に寄生したマラリア原虫は肝臓の細胞に入り増殖し、次に赤血球内で無性生殖により分裂増殖を繰り返します(右の画像:丸い赤血球の中にいる紫色の物体)。その中の一部原虫は有性生殖を行なうためにオスやメスの生殖母体に発育した後、再び蚊に吸われて蚊の中腸内に戻ります。オスやメスがあるのは動物や植物だけではなく単細胞である原虫もまた、オスやメスがあります。
原虫は、生活環境に適応するために様々な仕掛けを持っていて、細胞の中にいろいろな機能を持った特別な器官を発達させたり、オスやメスに分かれたり、減数分裂したり、特殊な壁を形成したりして複雑で不思議な面白い(生き物)細胞です。


雌蚊の吸血してから1日経った卵巣内の卵の切片像

学生と小川に住む巻貝や小魚を採取


肝蛭(カンテツ)の生鮮(生きた)像と染色像(保存用に固定して臓器がわかる様に色をつけたもの)
*肝蛭とは:
肝蛭は牛の肝臓の胆管に寄生する吸虫です。
肝臓の胆管で卵を産み、その卵は40−50mある牛の腸を通って糞便とともに外界に排出されます。
運良く卵が池や小川に流されると水中で孵化し、幼生が水中のヒメモノアラガイ(右の写真:姫物洗貝)の体の中に入って成長します。その後、貝から幼虫が出て水草について固い殻を作って蛹の様に次の機会(牛に食べられるまで)待ちます。牛に食べられると腸で殻から出て腸からお腹の中(腹腔)に入って肝臓を探します。肝臓を探し出すと今度は最終到達点の胆管まで肝臓内を移動しながら成長し成虫になり卵を産み始めます。
©️ 2020 The Society for Landscape Observation and Research. All Rights Reserved.